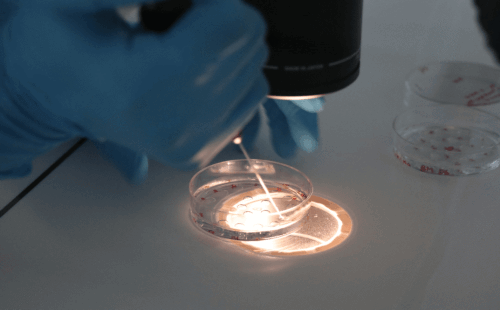
广西优孕助孕：广西妇幼保健院试管婴儿指南

本指南旨在为计划在广西优孕助孕并考虑广西壮族自治区妇幼保健院试管婴儿服务的家庭提供信息。文章将涵盖相关费用、医院技术以及广西的生育政策,并融入代生、代怀、供卵代怀等关键词,帮助有需要的家庭了解并做出适合的决定。
广西优孕助孕费用
广西优孕助孕费用是许多家庭关注的焦点。在广西壮族自治区妇幼保健院进行试管婴儿,其费用会因个体情况和所选试管技术(一代、二代、三代)的不同而有所差异。一般来说,费用范围可能在3-10万元之间。其中,第一代试管婴儿费用相对较低,约2-3万元;第二代试管婴儿费用在3-5万元;而第三代试管婴儿费用则可能在6-10万元。这些仅为预估费用,实际费用还可能受到当地经济水平、医院技术能力等因素影响。对于希望通过代生或代怀实现生育的家庭,了解这些基本费用非常有帮助。
广西壮族自治区妇幼保健院试管婴儿怎么样
广西壮族自治区妇幼保健院(亦称广西壮族自治区儿童医院)的生殖医学中心成立于2001年3月,是经国家卫生部批准开展人类辅助生殖技术的医疗机构。中心拥有一支经验丰富、技术精湛的专业团队,主要开展项目包括常规体外受精-胚胎移植、丈夫精子人工授精、卵胞浆内精子显微注射以及植入前胚胎遗传诊断等。这些先进的技术为许多不孕不育家庭带来了希望,也为供卵代怀提供了技术支持。医院致力于提供高质量的辅助生殖服务,以提高试管婴儿的成功率。女性的年龄、染色体、精卵质量、宫内环境、心理状态以及医疗技术水平等多种因素都会影响试管婴儿的成功率。
广西壮族自治区人口和计划生育条例(2026年修正)
广西壮族自治区人口和计划生育条例(2026年修正)为生育家庭提供了政策指导。条例规定了生育调节、计划生育技术服务、奖励与社会保障以及管理措施等多个方面。对于有再生育意愿的家庭,特别是需要代生套餐或寻求代怀电话咨询的家庭,了解相关政策至关重要。例如,条例明确了符合特定条件可以再生育的规定,以及对计划生育特殊家庭的扶持政策。
2026年1月26日:下发了《广西壮族自治区计划生育特殊家庭辅助生育服务实施方案(试行)》
为了进一步帮助计划生育特殊家庭实现再生育的愿望,广西壮族自治区于2026年1月26日下发了《广西壮族自治区计划生育特殊家庭辅助生育服务实施方案(试行)》。该方案规定,符合条件的计划生育特殊家庭(如独生子女死亡或伤残)在接受试管婴儿等辅助生殖技术治疗时,最高可获得5万元的补贴。这一政策极大地减轻了这些家庭的经济负担,为他们通过供卵包成功等方式实现生育提供了有力的支持。该方案明确了服务对象、申请条件以及补助标准,为有需要的家庭提供了详细的指导。
温馨提示
针对皮肤健康,虽然与助孕直接关系不大,但保持良好的身体状态是成功进行生育治疗的基础。如有皮肤方面的疑问,建议咨询专业医生。